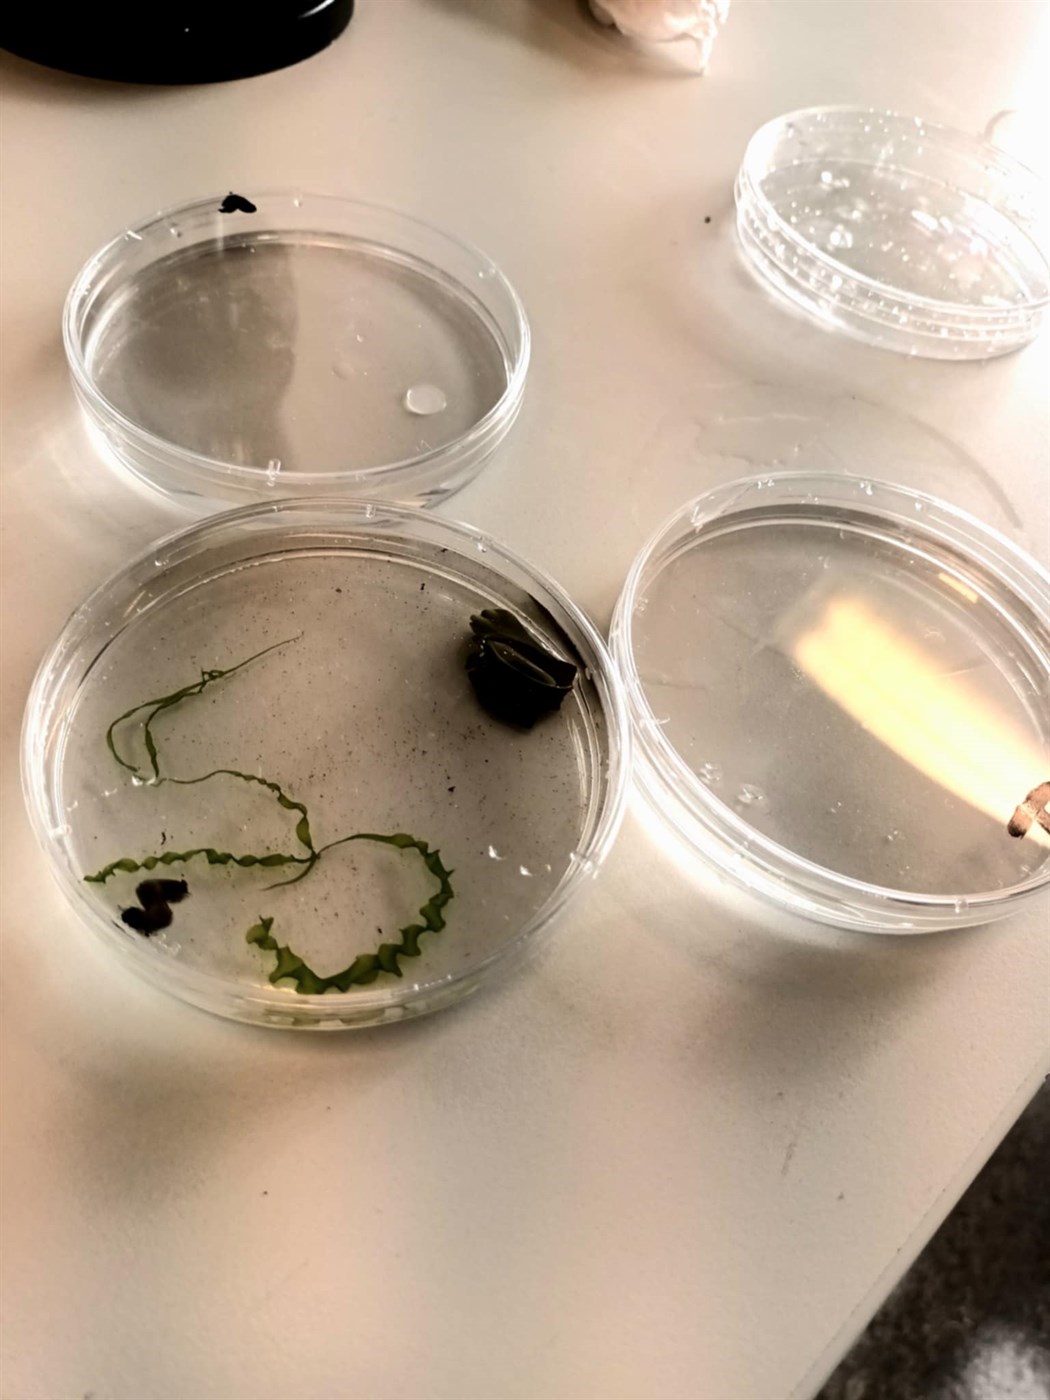

UNESCO

Frá því að við gengum í UNESCO tengslanetið (ASPnet) árið 2025, höfum við innleitt UNESCO gildin í daglegt starf skólans. Áhersla okkar hefur verið á heimamenningu, umhverfisvitund og alþjóðlegt samstarf.
Í 3. bekk taka nemendur þátt í vikulegum UNESCO tímum þar sem fjallað er um jafnrétti, baráttu gegn fordómum, menningarvitund og umhverfisábyrgð. Nemendur hanna veggspjöld, miðla upplýsingum til samfélagsins og skipuleggja UNESCO-þemadaga.
Staðsetning okkar við Reykjanes UNESCO jarðvang (Geopark) gefur okkur einstakt tækifæri til að tengja hnattræn markmið við staðbundinn veruleika. Á þessu ári tókum við á móti kennurum frá Frakklandi og Ítalíu, sem gaf nemendum og starfsfólki tækifæri til að kynna starf sitt og efla alþjóðleg tengsl.
Nýjasta verkefnið okkar snýst um vatn - mikilvæga auðlind og kjörið viðfangsefni fyrir verklega kennslu. Hvort sem við erum að rannsaka sjávarsíðuna, tjarnir eða regnvatn, veitir þetta verkefni nemendum innsýn í sjálfbærni og verndun vatnsauðlinda.